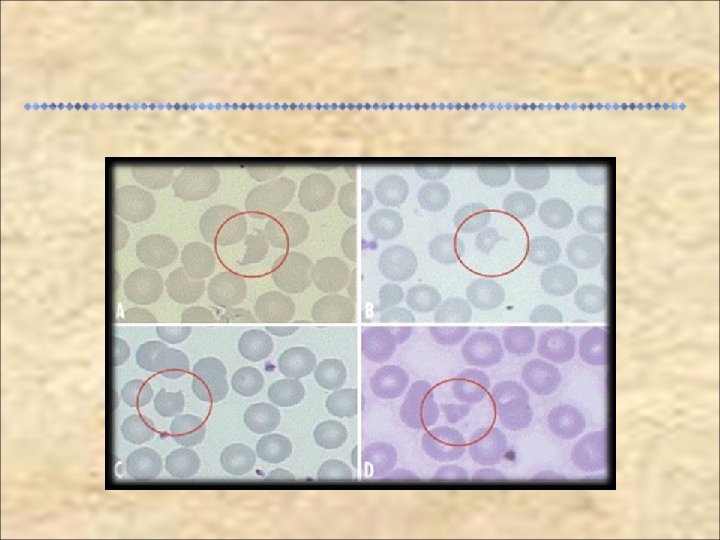

MONOGRAFIA APRESENTADA NA CONCLUSO DE RESIDNCIA MDICA EM






















- Slides: 22

MONOGRAFIA APRESENTADA NA CONCLUSÃO DE RESIDÊNCIA MÉDICA EM PEDIATRIA DO HOSPITAL REGIONAL DA ASA SUL, BRASÍLIA, DF CAMILA AMARAL VENUTO Orientador: Dr. Jefferson Augusto Piemonte Pinheiro www. paulomargotto. com. br 11/11/2009

Causa mais comum de IRA em crianças Potencial para evoluir como processo auto-limitado Formas típica e atípica Subdiagnóstico Crianças de 1 a 10 anos de idade (<5 anos), características indistinguíveis de GECA 5, 8 casos/100. 000 crianças < 5 anos/ano nos EUA Santa Casa de São Paulo (1978 a 1996): 34 casos Espié Pediatr Infect Dis, 2008; Michael Am J Kidney Dis, 2009; Andrade Nefrologia Pediátrica, 2006

Realizar revisão da literatura sobre a síndrome hemolíticourêmica visando atualizar as informações aos profissionais de saúde, a fim de melhorar o diagnóstico da doença e conseqüentemente diminuir suas complicações.

Revisão da literatura nacional e internacional utilizando os bancos de dados MEDLINE, LILACS-BIREME e COCHRANE Delimitadores: crianças; 3) pneumoniae Artigos originais, de revisão, editoriais e diretrizes escritos nas línguas inglesa e portuguesa nos últimos 12 anos 1) síndrome hemolítico-urêmica; 2) Escherichia coli; 4) Streptococcus

1925 – Moschowitz: anemia hemolítica microangiopática, petéquias, hemiparesia e febre trombos hialinos 1955 – Conrad Gasser: anemia hemolítica, plaquetopenia e IRA 1977 – Klein et al. : P-SHU 1981 – Thompson e Winterborn: sistema complemento na fisiopatologia 1983 – Karmali et al. : presença de STEC em amostras fecais 1998 – Descoberta de herança genética (mutação fator H) Surtos: Europa (1992), Reino Unido (1994) e Japão (1996) Mc. Care Hematology, 2008 Razzaq Am Fam Physician, 2006 Scheiring Pediatr Nephrol, 2008

70% - 95% dos casos relacionados a E. coli. (O 157: H 7, O 26: H 11 e O 123), Enterobacter, Shigela, Citrobacter 5 - 18% dos pacientes infectados por E. coli enterohemorrágica evoluem com SHU Chance de desenvolver a doença depende de: infectividade da cepa imunidade ao microrganismo tipo de resposta do hospedeiro predisposição genética Mc. Crae Hematology, 2008 Cleary Semin Pediatr Infect Dis, 2004

Stx 1 e Stx 2: LPS (outras: subtilase, toxina “cytolethal distending” e inibidora da C 1 esterase); receptor Gb 3 supra-regulação de citocinas pró-inflamatórias (IL, INF) e dos receptores Gb 3 estímulo à resposta inflamatória, recrutamento de neutrófilos e monócitos Stx + Gb 3: endocitose e transporte para complexo de Golgi e retículo endoplasmático inativação irreversível de ribossomos e da síntese proteica lesão e morte celular, Mc. Crae Hematology, 2008 Scheiring Pediatr Nephrol, 2008 Bavaro Current Gasroenterology Reports, 2009

Perda da integridade da vasculatura coagulopatia (ativação de plaquetas, expressão de fator tecidual e falha do ADAMTS 13, com liberação de multímeros anormalmente grandes do FVW) alterações prótrombóticas na cascata da coagulação e anemia hemolítica Geração de trombos e inibição da fibrinólise ocorrem antes de instalada a SHU Mc. Crae Hematology, 2008 Scheiring Pediatr Nephrol, 2008 Bavaro Current Gasroenterology Reports, 2009

10 – 15% dos casos da patologia Infecções: pneumococo, HIV, Bartonella, Epstein Barr Drogas (ciclosporina, mitomicina C, ganciclovir, contraceptivos orais, drogas ilícitas - crack), e doenças sistêmicas (LES, leucemia, GNPE, reação pós transplante de medula óssea) Herança genética dominante ou recessiva (50%) Via alternativa do sist. complemento (FH, MCP, FI, FB) Auto-anticorpos (DEAP SHU) Alterações na coagulação (falha do ADAMTS 13) Avner Pediatrics, 2007 Skerka Molecular Immunology , 2009 Edney Am J Kidney Dis, 2008

Sistema complemento; multímeros do FVW Predisposição + dano endotelial (infecções, drogas, doenças sistêmicas, gestação, neoplasia) = doença Alterações genéticas: tipo I e tipo II Pneumococo (40%): neuraminidase desialinização de glicoproteínas da membrana celular de eritrócitos, plaquetas e células glomerulares exposição do antígeno-T e reação com Ig. M anti-T circulante agregação plaquetária e dano direto a células endoteliais Kavanagh British Medical Bulletin, 2006 Jokiranta Molecular Immunology, 2007 Waters J Pediatr, 2007

Microangiopatia trombótica Diversos órgãos Arteríolas: deslizamento de células endoteliais exposição da membrana basal, oclusão, depósito de fibrina Glomérulos: retração e perda do contorno dos capilares, proliferação LEROSE SC E miointimal, edema e necrose Depósito de C 3, Ig. M e ÇÃO A TR AR L fibrinogênio I UL INF B TU O PL NO U D OR NT CO O SÃ L N IA PA EX ANG S ME Scheiring Pediatr Nephrol, 2008 Kanso Brenner and Rector’s Kidney, 2007

Idade < 5 anos, sexo feminino Durante infecção por STEC: infecção pelo sorotipo O 157, leucocitose (>20. 000), altos níveis de PCR, febre, diarréia sanguinolenta, náuseas e vômitos Uso de anti-diarréicos Uso de antibiótico em crianças com colite hemorrágica associada a EHEC: controverso Durante infecção parapneumônico pneumocócica: empiema Bell Pediatrics, 1997 Cestari Rev Paul Pediatr, 2008

Palidez súbita, falência renal aguda , febre (baixa ou ausente) Recuperação renal em 2 – 3 semanas SHU incompleta: sem falência renal Correlação entre histologia renal do início da doença e sua evolução: necrose cortical lesão renal crônica Aparente recuperação renal pode ser seguida de declínio secundário Mc. Crae Hematology, 2008 Gianviti Pediatr Nephrol, 2003 Brandt Pediatrics, 2007

RENAIS *Insuficiência renal crônica *Hipertensão *Proteinúria / hematúria GASTRINTESTINAIS *Perfuração intestinal *Intussuscepção *Pancreatite *Colite SISTEMA NERVOSO CENTRAL *Alterações do nível de consciência *Convulsões *Sintomas focais MÚSCULOS *Rabdomiólise *Lesão miocárdica OFTALMOLÓGICAS *Descolamento de retina *Hemorragia coroidal *Hemorragia vítrea *Trombose da artéria retiniana Possíveis complicações de SHU Razzaq Am Fam Physician , 2006 Anis Pediatr Nephrol, 2007

Etiologia da doença, tempo de oligúria/anúria, duração da necessidade de diálise, comprometimento do SNC, hipertensão arterial, colite isquêmica Leucograma e níveis séricos de uréia, creatinina, PCR e interleucinas Seguimento ambulatorial até idade adulta Avaliação periódica da microalbuminúria detecção precoce de queda de função renal Mc. Crae Hematology, 2008 Brandt Pediatrics, 2007 Kanso Brenner and Rector’s kidney, 2007

Determinação etiológica C 3, C 4, FH, FB, FHR 1 e FI; auto-anticorpos (Ig. G) Culturas e sorologias Achados hematológicos: anemia hemolítica com Coombs negativo, plaquetopenia, leucocitose Função renal: EAS, urina de 24 h, níveis séricos de uréia e creatinina Indicadores de hemólise: DHL e PCR haptaglobulina , , hiperbilirrubinemia indireta Exames de imagem (comprometimento neurológico): RNM Provas de coagulação: Outros: amilase, lipase, função fibrinogênio, tempo de protrombina hepática e de tromboplastina normais Exames complementares que podem ser necessários Mc. Crae Hematology, 2008 Razzaq Am Fam Physician,

Critérios laboratoriais para diagnóstico: Anemia aguda com alterações microangiopáticas Lesão renal aguda evidenciada por hematúria, proteinúria ou elevação dos níveis de creatinina Plaquetopenia pode acontecer, mas não é obrigatório que seja detectada no início da instalação da doença. No entanto, se os níveis de plaqueta sete dias após o início de diarréia aguda não for < 150. 000/mm 3 outro diagnóstico deve ser considerado CDC, 1996

ABDOME AGUDO - Apendicite Dor abdominal piora com o tempo, abdome tenso, com defesa à palpação GASTROENTERITE AGUDA Dor abdominal menos intensa, defecação não é dolorosa. COLITE Não há febre, aumento da contagem de leucócitos em amostra fecal CIVD Baixos níveis de fibrinogênio, tempo de protrombina e de tromboplastina parcial alargados DOENÇA INFLAMATÓRIA Diarréia alternante com constipação, náuseas, perda INTESTINAL ponderal, febre alta INTUSSUSCEPÇÃO Fezes tipo geléia de amora, cólicas episódicas LUPUS Ausência de anticorpos anti-plaquetários, presença de anticorpos antifosfolípedes TROMBOCITOPENIA Anormalidades neurológicas mais graves TROMBÓTICA Principais diagnósticos diferenciais de SHU Razzaq Am Fam Physician, 2006

Terapia de suporte: aporte nutricional e equilíbrio hidreletrolítico Expansão volumétrica parenteral diminui conseqüências da formação de trombos na microvasculatura Tratamento da falência renal aguda: diálise Tratamento da hipertensão: IECA Plasmaferese e plasma fresco congelado Transfusão de hemoderivados Antibioticoterapia Transplante Razzaq Am Fam Physician, 2006 Garg JAMA, 2003 S cheiring Pediatr Nephrol, 2008

Doença com expressiva prevalência na população pediátrica Identificação rara no serviço de emergência: subdiagnóstico Comprovação da etiologia na maioria das vezes não é feita, devendo ser estimulada Medidas preventivas Seguimento a longo prazo

“Não há no mundo exagero mais belo que a gratidão. ” Jean de La Bruvère